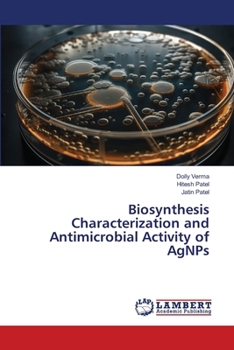
Paperback Biosynthesis Characterization and Antimicrobial Activity of AgNPs Book

Biosynthesis Characterization and Antimicrobial Activity of AgNPs
In this study, researchers focused on selecting Bambusa Arundinaceae (Bamboo) and Euphorbia Hirta plants for synthesizing silver nanoparticles (AgNPs). These plants were chosen for their diverse medicinal properties. The FTIR analysis provided valuable information about the structure of the synthesized nanoparticles, confirming the presence of characteristic bands associated with silver nanoparticles in both Bamboo and Euphorbia samples. These bands indicated the formation of stable AgNPs and suggested the involvement of specific functional groups from the plant extracts in the reduction and stabilization process. The antimicrobial activity of the synthesized AgNPs was also evaluated against pathogenic organisms. The results demonstrated potential antimicrobial efficacy for both Bamboo and Euphorbia nanoparticles. However, further investigations are needed to elucidate the exact mechanism underlying their antimicrobial activity. In summary, this study successfully synthesized silver nanoparticles using an eco-friendly approach by employing Bamboo and Euphorbia leaf extracts as reducing agents.
Format:Paperback
Language:English
ISBN:6206737616
ISBN13:9786206737612
Release Date:January 2024
Publisher:LAP Lambert Academic Publishing
Length:64 Pages
Weight:0.23 lbs.
Dimensions:0.1" x 6.0" x 9.0"
Customer Reviews
0 rating